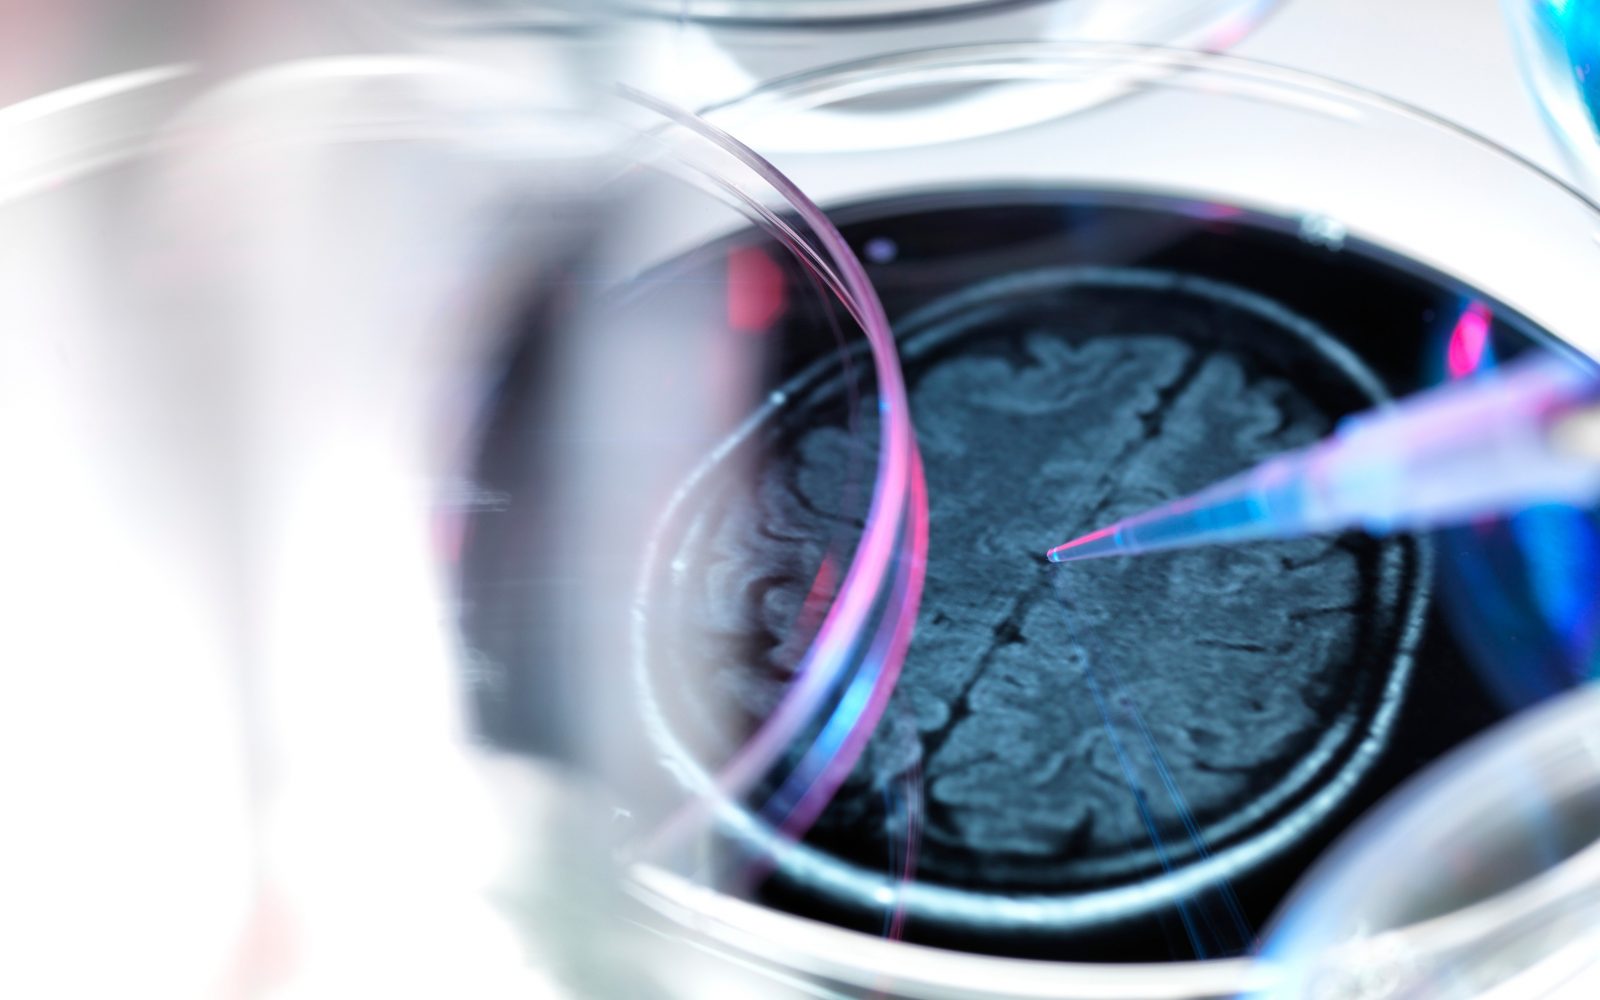

Prav zato smo se v digitalnem posvetu Triglav, Zdravstvene zavarovalnice pogovarjali z nevrologom prof. dr. Zvezdanom Pirtoškom, ki je odkrito spregovoril o demenci, kako so nanjo zdravniki gledali včasih, kako na to bolezen gledamo danes, kaj kažejo zadnje študije, kako je z zdravljenjem in kaj lahko za svoje zdravje naredi vsak sleherni posameznik.
Kot vemo, ima demenca več podtipov bolezni, najpogostejša pa je Alzheimerjeva bolezen, ki prizadene okoli 70 odstotkov obolelih.
“Zdravniki pod besedo demenca razumemo upad višjih miselnih funkcij, kot so spomin, orientacija v prostoru, govor, sposobnost branja, seštevanja, odštevanja,” našteva dr. Pirtošek. Dodaja, da so tu še vedenjske značilnosti, kako se oseba v določenem okolju obnaša. Če sta vsaj dve od omenjenih miselnih funkcij okrnjeni do te mere, da bolnik zaradi tega ne more več normalno delovati, govorimo o demenci.
10 do 15 odstotkov demenc je ozdravljivih
Vzroki demence so po besedah dr. Pirtoška lahko zelo različni. Pojasnjuje, da lahko zdravniki ob znakih demence najprej pomislijo prav na Alzheimerjevo bolezen, saj je daleč najpogostejša. Ob tem pa so najbrž vsi zdravniki najbolj srečni, če ugotovijo, da je razlog za demenco ozdravljiv: “Približno 10 do 15 odstotkov demenc je takšnih, ki so ozdravljive. Imenujemo jih reverzibilne demence. Če bo k zdravniku prišlo 100 bolnikov z demenco, jih bo približno 10 ali 15 imelo take vrste demenco.“

Čeprav je reverzibilna demenca statistično manj verjetna kot Alzheimerjeva bolezen, je za zdravnika dejstvo, da lahko pomaga, tako pomembno, da bo že na samem začetku diagnostične poti iskal takšno obliko demence: “Razlogi so lahko pomanjkanje vitamina B12, nekatere žilne bolezni, slabo delovanje ščitnice, tumor v možganih in tako dalje. Zato bomo zdravniki bolniku zelo zgodaj v diagnostičnem postopku vzeli kri in pogledali delovanje ščitnice, ali ima dovolj vitamina B12, obenem mu bomo slikali možgane, da ne spregledamo tumorja ali česa podobnega.“
Dr. Pirtošek pojasni, da “čim starejši smo, bolj verjetno je, da imamo Alzheimerjevo demenco“. Demence se namreč običajno pojavijo ob določenem času. Pravi, da se bo tipična Alzheimerjeva demenca pojavila okoli 70. leta, tipična demenca zaradi delovanja ščitnice ali pomanjkanja vitamina B12 pa, statistično gledano, veliko prej.
Dodaja, da je majhen del teh demenc tudi genetski in povezan s tremi geni. Če ima oseba katerega od teh treh genov, je kar 50 odstotkov možnosti, da bodo za to obliko zboleli tudi potomci: “Ampak tu gre za veliko manjšino demenc, to niso navadne Alzheimerjeve demence.“
Bodite pozorni na znake
“Zdravniki ugotavljamo, da je demenca zelo logična bolezen. Če pogledamo možgane, vidimo, da imamo v zadnjem delu različne centre, na primer center za spomin, center za orientacijo, imamo center zato, da razumemo govor, center za vidne informacije in tako dalje. Za Alzheimerjevo demenco je značilno, da zajame prav te dele možganov, točno te centre, ki sem jih naštel,” našteva dr. Pirtošek.
Nevrolog je opozoril tudi na razliko med “normalnim” pozabljanjem zaradi starosti in pozabljanjem, ki lahko zaskrbi. Pozabljanje je namreč del staranja, saj naši možgani s starostjo vsako leto izgubljajo tudi na teži. “Pozabimo, kam smo dali ključe, morda se ne moremo spomniti imena osebe, s katero govorimo, morda trikrat na teden nekaj založimo in potem najdemo, ali se nam zgodi dvakrat, trikrat na teden, da pozabimo ime sosede, ki živi v spodnjem stanovanju. Pa se potem čez dvajset minut spomnimo tega imena … V tem primeru gre za normalno staranje,” opisuje. Skrbeti nas mora, če je takšnih pozabljivosti čez dan veliko; da na primer ne vemo, kje so ključi in jih potem nekdo najde na nenavadnem mestu, ali če se nikakor, tudi več ur kasneje, ne moremo spomniti imena spodnje sosede in tako naprej.
Demenco lahko opazimo veliko prej
Dr. Zvezdan Pirtošek pojasnjuje, da se demenca začne že nekaj desetletij pred tem pozabljanjem, ki nam povzroča težave. Alzhemerjeva demenca se po njegovih besedah začne že v 40., 50. letih, izrazi pa se približno dvajset let kasneje.
Spominja se, da je pred 20. ali 30. leti dobil v ambulanto že tako strte bolnike z demenco, da jim ni mogel pomagati. In da so njegovi kolegi, ki so sprejeli bolnika s hudo demenco, svetovali skrbnikom, da pazijo nanj ali naj ga dajo v dom. “In tudi dejansko zdravniki takrat nismo mogli veliko pomagati. Ni bilo diagnostičnih sredstev in ni bilo terapije. V zadnjih 20 letih se je to močno spremenilo,” dodaja.
Obenem zdaj vemo, da se bolezen začne veliko prej in da je zgodnje diagnosticiranje zelo pomembno. Pogosto pridejo v ambulanto tudi bolniki, pri katerih se demenca še ni izrazila.
“Danes vemo, da se začne ta bolezen prej in z zelo subtilnimi znaki,” opisuje, “in s tako imenovano subjektivno kognitivno pritožbo“. Kot primer opsuje osebo v poznih 40. letih, ki se ji zdi, da pozablja več kot njeni kolegi. Tudi če zdravniki v tem trenutku ne morejo ugotoviti, ali gre res za zgodnjo obliko demence, lahko takšnega bolnika spremljajo, saj je po raziskavah 30 odstotkov možnosti, da se bo pri njem v naslednjih nekaj letih res razvila zgodnja demenca.
Naslednja stopnja, ki jo dr. Pirtošek opisuje, je tako imenovana blaga kognitivna motnja, ki pa jo že lahko potrdi nevropsiholog. Ta bolnik ima v svojih možganih že bolezen, a lahko še vedno v družbi, službi itd. normalno deluje.
O naslednji stopnji, tako imenovani blagi Alzheimerjevi demenci, je govora, ko se začne posameznik zaradi težav delati napake v službi, pojavijo se težave v družbi itd. Statistike kažejo, da se subjektivna kognitivna pritožba lahko pojavi okoli 45. leta, blaga kognitivna motnja okoli 55. leta, v 65. letu življenja pa se nato razvije zgodnja demenca.

Kaj lahko naredi bolnik sam?
Dr. Pirtošek je podal tudi nasvet za tiste, pri katerih odkrijejo blago kognitivno motnjo, saj lahko k razvoju bolezni nekoliko pripomorejo tudi sami.
“V zadnjih letih je prišlo v medicinske časopise veliko študij, ki dajo zelo jaso optimistično sporočilo. Pokazalo se je, da imamo nek niz ukrepov, načinov življenja, ki nas bodo pahnili v demenco, tudi če smo samo na njenem robu. Ali pa če bomo obrnili slog življenja, jo bomo lahko prestavili za 7 morda 8 let. Tudi ko se bo pojavila, bo v lažji obliki. Imeli bomo kognitivno rezervo,” opisuje.
Kateri so ti slogi? Na prvo mesto je postavil fizično aktivnost, saj med drugim spodbuja rojevanje novih celic. Gibati se moramo vsaj 30 minut petkrat na teden ali 20 minut sedemkrat na teden. V tem času pa moramo imeti vsaj nekaj minut tudi aerobno vadbo, ki pospeši naše srce, da potisne kri proti možganom.
“Na drugo mesto bi dal neko otroško individualno radovednost. Nikoli v življenju se ne smemo prenehat čuditi, se učiti, imeti hobije. Če bomo intelektualno aktivni, se bodo naši možgani ohranili. Eden izmed lepih načinov je denimo učenje jezika,” pravi.
Tretja stvar, na katero opozarja, je mediteranska dieta.
“Četrta stvar, ki bi jo omenil, je spanje. Še pred nekaj leti se vloge spanja nismo zavedali. Jaz sem generacija zdravnikov, ki smo se celo hvalili, če celo noč nismo spali. Pokazalo se je, da tisti, ki malo spijo, plačajo v 60. in 70. letu svojega življenja s tem, da so bolj pozabljivi. Kognitivno nekoliko bolj oslabljeni,” opozarja. Koliko spanja potrebuje odrsala oseba, je zelo individualno, priporočljivo je od 7 do 9 ur: “Manj ali več od tega je slabo.“
“Potem je tu še izogibanje stresu. Kratkotrajni stres je nekaj zelo dobrega, nas naredi borce. Stres, ki traja tedne, mesece, leta, pa dobesedno fizično uničuje celice našega spominskega centra – hipokampusa,” pravi. Zato je po njegovih besedah zelo pomembno, da se poskušamo izogibati stresu. Ko pride do neizbežnega stresa, pa si poskušamo pomagati s sproščanjem, delamo nekaj, kar nas pomirja ali celo poiščemo strokovnjaka.
“To so te stvari, ki nam bodo pomagale. Če jih bomo zavestno negovali in gojili, nas bo morda demenca obiskala nekaj let kasneje. Upajmo, da bomo do tedaj že odkrili kakšno zdravilo za njeno preprečevanje,” je sklenil.
Temu rečemo starizem
Dr. Pirtošek, ki je tudi nevroznanstvenik, se je obregnil tudi ob tako imenovani starizem.
Pojasnjuje, da pride do tega zato, ker družba staranje in misel na starost, na smrt, umiranje odriva in se o tem ne želi pogovarjati. “Bojimo se pogovora o smrti, bojimo se misli, da bo moje telo nekoč postarano. Gre za strah pred lastno usodo,” opisuje.
Že v otroštvu, denimo skozi pravljice, začnemo graditi neko podobo o starem človeku. “Tisti, ki je drugačen od mene. Ironija starizma je, da v njem vidimo lastno podobo, ki je zdaj zarošena in vanjo ne želimo pogledati,” opisuje.
Kaj pa v poznejši fazi demence?
Tudi za poznejšo fazo demence je pomembno, da prejme bolnik čim prej diagnozo. “Ker bo po začetnem šoku lahko načrtoval svoje življenje, tudi ko bo vstopil v zelo pozno, bodo lahko nekatere stvari narejene, kot si jih je zamislil. Ta diagnoza je pomembna tudi za skrbnike, ki leta in leta živijo v prepričanju, da je oče hudoben in jih ne mara in jih zaradi tega skrbi,” opisuje nevrolog.
Tudi skrbniki se bodo mogli po njegovih besedah naučiti veščine pogovora s takim bolnikom, tudi če je ta agresiven. “Na koncu pride faza, ko bolnik ne prepozna svojih najbližjih,” pravi in opisuje, da mnogi bolniki čisto na koncu kličejo mamo, očeta, ki ju vidijo denimo v medicinski sestri.
Na podlagi tega lahko sklepamo, da v zadnjih dneh potrebujejo stik. Zato je pomembno, da smo tudi v dneh, ko nas bolnik ne prepozna, ob njem, saj bo čutil, da je z njim dobra oseba, ki ga pomirja. “V zadnji fazi pomagajo preprosto stisk roke, miren glas, občutenje, da je ob njem nekdo, ob katerem se bo bolnik počutil varnega,” opisuje.
Prihodnost z zdravili
Zadnje zdravilo je po besedah dr. Pirtoška prišlo na tržišče leta 2013, žal pa trenutno nimamo obetajočih podatkov za naprej: “Še najbolj zanimivi podatki prihajajo s področja antiteles proti amiloidu. Mi vemo, da se pri Alzhaimerjevi demenci v možgane nalagajo neke hudobne beljakovine amiloid. In veliko podjetij dela antitelesa proti amiloidu. Tukaj je precej obetajočih študij, ki pa naslednje tri leta zanesljivo ne bodo še dale rezultatov.“
Opozoril je tudi na pomen zadostnega števila zdravnikov, ki bi lahko nudili bolnikom hitro obravnavo in diagnozo. Pri tem dodaja, da zdravljenje izboljša stanje pri kar tretjini bolnikov, pri tretjini zaustavi oziroma odloži potek bolezni, pri tretjini pa žal ne pomaga. “Zato je tu odgovornost družbe, da pomaga osebam z demencami,” je zaključil nevrolog prof. dr. Zvezdan Pirtošek.
TUKAJ si oglejte posnetek digitalnega posveta z dr. Zvezdanom Pirtoškom
